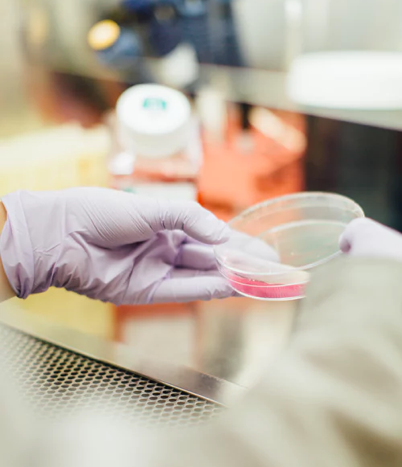
Sample 01

Precipita es una plataforma de crowdfunding especializada en proyectos científicos
Si participas en un proyecto de investigación científica en España y necesitas financiación, en Precipita podemos ayudarte
Te acompañaremos durante todo el proceso.
Si tienes cualquier duda, escríbenos a

